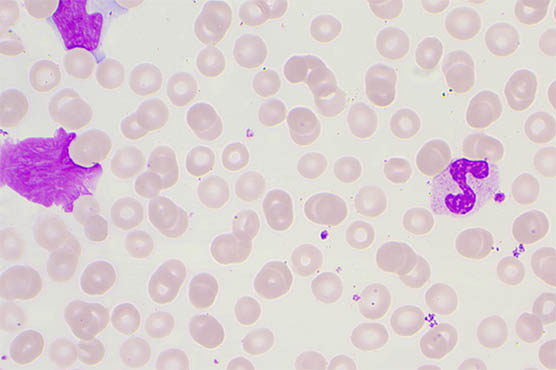

微信扫描二维码,点击右上角 ··· 按钮
转发给朋友或分享到朋友圈
荧光显微镜用于血液样品观察与分析
发布时间:2026-02-28
访问量:23
在自身免疫疾病或传染病的体外诊断中,间接免疫荧光显微镜技术可用于检测病人血液中的特定抗体。它可以经过软件检测与经培养的病人血清细胞的荧光图形,为实验室医生提供建议。

明美正置荧光显微镜MF43-N采用优良的无限远光学系统,6孔转盘式荧光模块设计,应用于生物制药,医学检测、疾病预防等领域。

荧光显微镜MF43-N采用人机工程学设计,操作简单、方便,减少工作中的疲劳,结构紧凑,性能稳定。可更方便地通过多种方法满足样品观察需求

100X放大下的血液细胞
荧光显微镜搭配2000万像素显微镜相机,可准确还原样品的惊喜结构和真实色彩,采用USB3.0数据传输接口,全分辨率下运行流畅,提升采集效率,是病理诊断的理想工具。
100X放大下的血液细胞
微信扫描二维码,点击右上角 ··· 按钮
转发给朋友或分享到朋友圈